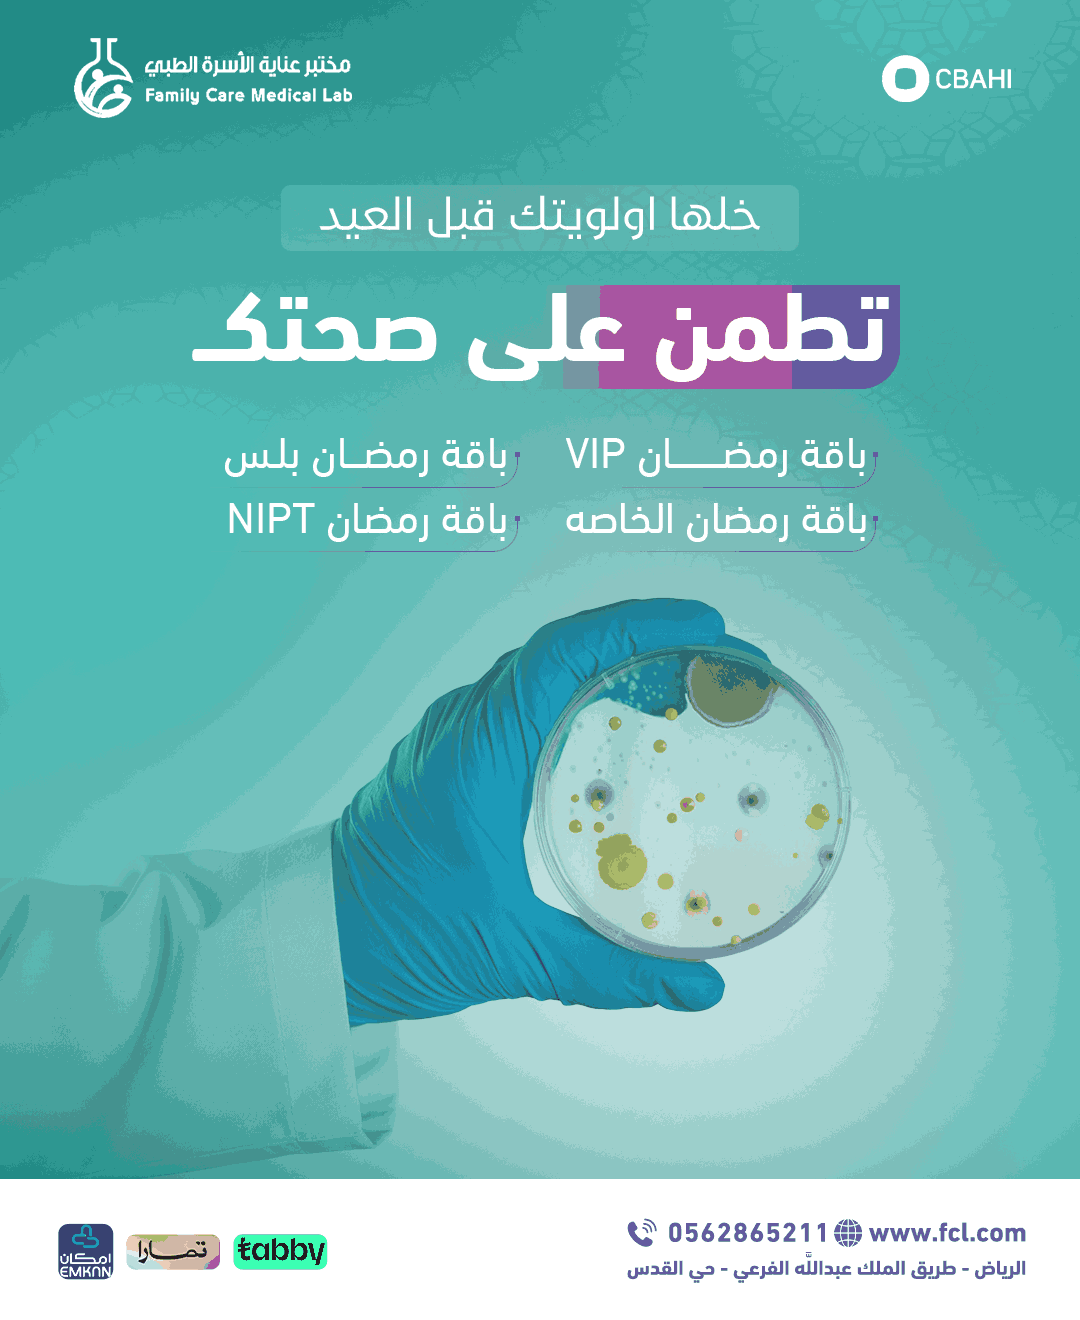
مختبر عناية الاسرة (2)

بعض من أعمالنا
تمكنا من تحقيق نجاحات كبيرة في مجالات مختلفة، منها التسويق والتجارة الإلكترونية
ونحن نفخر بأننا شركاء لعدد كبير من الشركات والمؤسسات الناجحة في المنطقة، ونسعى دائماً لتقديم الأفضل لعملائنا وتحقيق مزيد من النجاحات المشتركة. نحن نؤمن بأن العمل الجماعي و التعاون هما السبيل الوحيد لتحقيق النجاح المستدام، ونحن على استعداد دائم لتقديم الدعم والمساعدة لعملائنا في تحقيق أهدافهم وتحقيق النجاح المشترك.تعرف على خدماتنا إنقر هنا
وكالة إم دي للتسسويق معكم من الفكرة الى النجاح بإبداع متجدد و أدهاف محققة